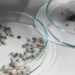
В Парижі почали знищувати комах, які переносять вірус денге – Світ

Правоохоронці повідомили про підозру 32-річному чоловіку за фактом жорстокого поводження з тваринами. За даними слідства, в серпні цього року на одній із вулиць м. Кам’янка-Бузька він вбив безпритульну собаку. Про це повідомили у Прокуратурі Львівської області.
“Чоловік наніс тварині численні удари розбитою скляною пляшкою, після чого руками задушив її”, — йдеться у повідомленні.
Слідчі дії тривають. Поліція відкрила кримінальне провадження за фактом жорстокого поводження з тваринами (ч. 1 ст. 299 ККУ).
За таке порушення загрожує пів року арешту або обмеження волі на строк до трьох років.
 львівськиЙ
львівськиЙ